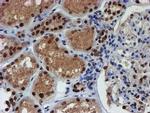
RFXANK Antibody in Immunohistochemistry (Paraffin) (IHC (P))

Search
Invitrogen
RFXANK Monoclonal Antibody (OTI2B6)
{{$productOrderCtrl.translations['antibody.pdp.commerceCard.promotion.promotions']}}
{{$productOrderCtrl.translations['antibody.pdp.commerceCard.promotion.viewpromo']}}
{{$productOrderCtrl.translations['antibody.pdp.commerceCard.promotion.promocode']}}: {{promo.promoCode}} {{promo.promoTitle}} {{promo.promoDescription}}. {{$productOrderCtrl.translations['antibody.pdp.commerceCard.promotion.learnmore']}}

Please note: We are reviewing Western blot images included in the antibody testing data in our catalog, including those provided by third parties. Unless expressly labeled or annotated as “raw-unedited”, Western blot images included in the antibody testing data in our catalog may have been edited, optimized or otherwise adjusted for presentation.
产品信息
MA5-25864
种属反应
宿主/亚型
分类
类型
克隆号
抗原
偶联物
形式
浓度
规格
纯化类型
保存液
内含物
保存条件
运输条件
RRID
靶标信息
Major histocompatibility (MHC) class II molecules are transmembrane proteins that have a central role in development and control of the immune system. The protein encoded by this gene, along with regulatory factor X-associated protein and regulatory factor-5, forms a complex that binds to the X box motif of certain MHC class II gene promoters and activates their transcription. Once bound to the promoter, this complex associates with the non-DNA-binding factor MHC class II transactivator, which controls the cell type specificity and inducibility of MHC class II gene expression. This protein contains ankyrin repeats involved in protein-protein interactions. Mutations in this gene have been linked to bare lymphocyte syndrome type II, complementation group B. Two transcript variants encoding different isoforms have been described for this gene, with only one isoform showing activation activity.
仅用于科研。不用于诊断过程。未经明确授权不得转售。
篇参考文献 (0)
生物信息学
蛋白别名: Ankyrin repeat family A protein 1; DNA-binding protein RFXANK; Regulatory factor X subunit B; Regulatory factor X-associated ankyrin-containing protein; RFX-B
基因别名: ANKRA1; RFXANK; RFXB
Entrez Gene ID: (Human) 8625




